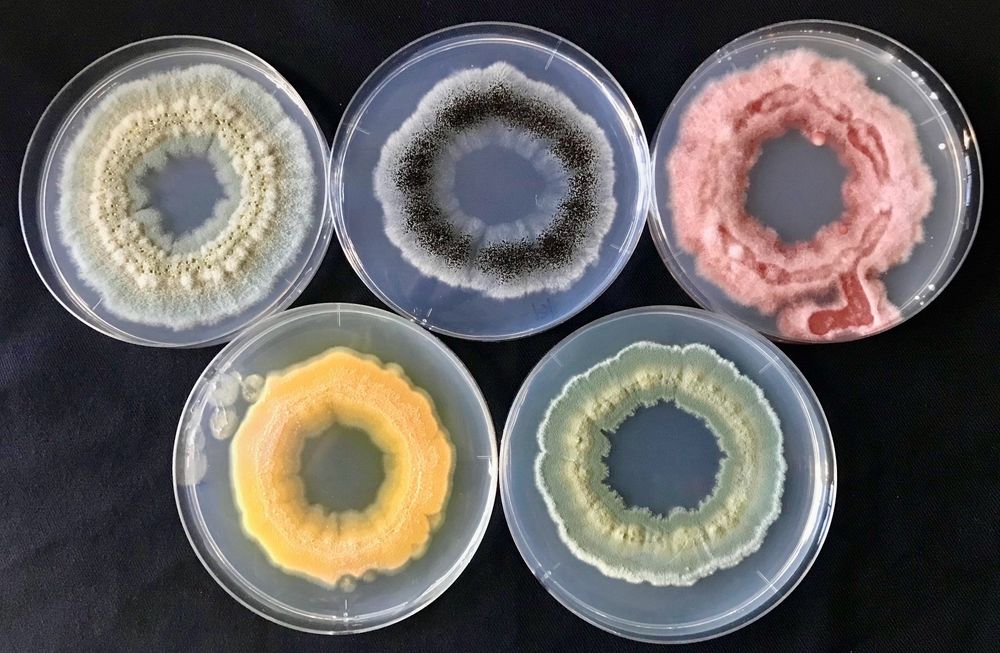

Version of Record, koji-kin 麹菌 @eLife
The increase in cell volume and nuclear number of the koji-fungus Aspergillus oryzae contributes to its high enzyme productivity.
elifesciences.org/articles/107...
Version of Record, koji-kin 麹菌 @eLife
The increase in cell volume and nuclear number of the koji-fungus Aspergillus oryzae contributes to its high enzyme productivity.
elifesciences.org/articles/107...

doi.org/10.7554/eLif...
doi.org/10.7554/eLif...
Koji-kin Aspergillus oryzae in Koji rice, invasive growth into steamed rice grain
Koji-kin Aspergillus oryzae in Koji rice, invasive growth into steamed rice grain